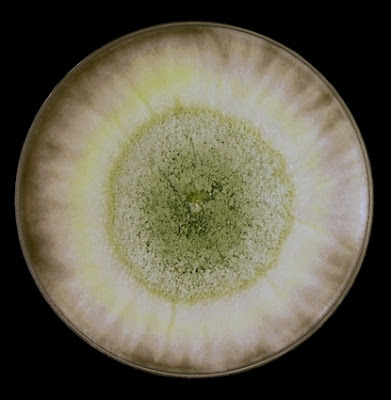
Colonia di Trichoderma su superficie muraria

Il Trichoderma è una delle muffe più diffuse nelle abitazioni italiane, facilmente riconoscibile per il suo caratteristico colore verde intenso. Se hai notato macchie verdi che si espandono rapidamente su pareti umide, carta da parati o nei pressi di condizionatori, potresti trovarti di fronte a questa particolare specie fungina. A differenza di altre muffe, il Trichoderma produce enzimi potenti e sostanze che possono influire sulla salute, soprattutto in persone con sistema immunitario compromesso. Riconoscerlo tempestivamente e sapere come intervenire è fondamentale per mantenere un ambiente domestico salubre. In questa guida scoprirai come identificare il Trichoderma, quali rischi comporta per la tua famiglia e quali soluzioni concrete adottare per eliminarlo definitivamente dalla tua casa.
Il Trichoderma è un genere di funghi filamentosi appartenente alla famiglia delle Hypocreaceae, particolarmente adattato agli ambienti umidi delle nostre abitazioni. Questo microrganismo si distingue dalle altre muffe per alcune caratteristiche specifiche che lo rendono facilmente riconoscibile ma anche particolarmente insidioso.
Le colonie di Trichoderma mostrano un comportamento di crescita caratteristico: inizialmente appaiono come macchie bianche e lanuginose, simili a batuffoli di cotone. Nel giro di pochi giorni, però, sviluppano il tipico colore che va dal verde giallastro al verde intenso, spesso concentrato in piccole aree o distribuito in zone concentriche ad anello.
Dal punto di vista microscopico, i conidiofori (le strutture che producono le spore) sono ripetutamente ramificati e portano grappoli di fialidi a forma di fiasco. Questa particolare morfologia consente al fungo di produrre enormi quantità di spore, che si diffondono facilmente nell'aria domestica.
Una caratteristica distintiva del Trichoderma è la sua capacità di crescere rapidamente in un ampio spettro di temperature, tipicamente tra 25 e 30°C, condizioni comuni nelle nostre case durante gran parte dell'anno. Alcuni ceppi particolarmente resistenti riescono a svilupparsi anche a temperature di 45°C, rendendoli presenti anche vicino a fonti di calore come termosifoni o caldaie.
Il fungo secerne enzimi proteolitici che compromettono le condizioni di crescita delle altre muffe circostanti. Questo spiega perché, quando si trova Trichoderma in casa, solitamente si presenta da solo senza altre specie fungine nelle immediate vicinanze.
Il Trichoderma rappresenta una minaccia concreta per la salute domestica, particolarmente per alcuni gruppi di persone. Il fungo produce piccoli peptidi tossici che, una volta assorbiti dalle cellule umane, causano l'ostruzione dei canali ionici che trasportano potassio e sodio attraverso la membrana cellulare.
Le manifestazioni cliniche associate all'esposizione al Trichoderma includono:
La normativa italiana non prevede limiti specifici per il Trichoderma negli ambienti indoor, ma le Linee Guida dell'ISS per la qualità dell'aria interna raccomandano di mantenere la concentrazione di spore fungine totali al di sotto delle 500 UFC/m³ (Unità Formanti Colonia per metro cubo d'aria).
Le specie più significative che possono colonizzare gli ambienti domestici sono:
L'identificazione del Trichoderma in casa richiede un approccio sistematico che combina osservazione visiva e, quando necessario, analisi di laboratorio specialistiche.
I luoghi di maggiore sviluppo in ambito domestico includono:
La rimozione del Trichoderma deve essere eseguita con particolare attenzione, poiché durante le operazioni di pulizia il fungo tende a rilasciare massivamente le spore nell'ambiente. È fondamentale seguire un protocollo specifico:
1. Valutazione preliminare: Prima di qualsiasi intervento, è consigliabile eseguire un'indagine microbiologica mediante campionamento dell'aria con aspiratore SAS (Surface Air System) per quantificare la contaminazione.
2. Protezione individuale: Utilizzare sempre mascherine FFP2 o FFP3, guanti monouso e indumenti protettivi per evitare l'inalazione delle spore.
3. Isolamento dell'area: Sigillare la zona contaminata con teli di plastica per evitare la diffusione delle spore verso altre aree della casa.
4. Sanificazione mirata: Applicare soluzioni fungicide specifiche, preferibilmente a base di ipoclorito di sodio allo 0,5% o perossido di idrogeno al 3%.
5. Rimozione dei materiali compromessi: Eliminare definitivamente carta da parati, cartongesso o altri materiali porosi gravemente contaminati.
6. Controllo dell'umidità: Ridurre l'umidità relativa dell'ambiente sotto il 50% mediante deumidificatori o miglioramento della ventilazione.
Un monitoraggio post-intervento è essenziale per verificare l'efficacia della sanificazione. Si raccomanda di effettuare un nuovo campionamento dell'aria dopo 15-30 giorni dalla bonifica.
Se vuoi capire nel dettaglio come funziona la come si diagnostica la patologia edile — strumentazione utilizzata, cause individuate e soluzioni consigliate — trovi tutto nella pagina del servizio.

Temi che in casa tua possano esserci muffe pericolose per la salute? L'unico modo per scoprirlo è un'indagine microbiologica: un tecnico viene direttamente a casa tua, preleva campioni dalle pareti e dall'aria, e dopo l'analisi in laboratorio ricevi una relazione tecnica con l'identificazione certa delle specie fungine e il livello di contaminazione del tuo ambiente domestico. Il servizio è eseguito con il supporto di laboratorio specializzato.
Indagine microbiologica specialistica: 500 €, tasse comprese.
Se necessario, possiamo anche effettuare test di efficacia dei sanificanti sul tipo di muffa individuato, per garantire che l'intervento di bonifica sia mirato ed efficace.
Prezzi riferiti ad appartamenti fino a 100 m², escluse eventuali spese di trasferta.
📍 Servizio attivo nelle province di Salerno e Avellino.
Il Trichoderma è più pericoloso di altre muffe comuni come Aspergillus o Penicillium?
Il Trichoderma presenta caratteristiche uniche che lo rendono particolarmente insidioso: la produzione di peptidi tossici e la capacità di crescere molto rapidamente. Tuttavia, ogni specie fungina ha i suoi rischi specifici. La pericolosità dipende principalmente dalla quantità di spore presenti nell'aria e dal tempo di esposizione.
Posso utilizzare la candeggina normale per eliminare il Trichoderma?
La candeggina domestica può essere efficace sulle superfici non porose, ma per il Trichoderma si consigliano soluzioni più specifiche. L'ipoclorito di sodio allo 0,5% è preferibile perché mantiene un'azione fungicida prolungata. Su materiali porosi come cartongesso, spesso è necessaria la rimozione completa del materiale contaminato.
Quanto tempo serve per eliminare completamente il Trichoderma da casa?
I tempi variano in base all'estensione della contaminazione e alle cause scatenanti. La sanificazione immediata richiede 2-3 giorni, ma il controllo definitivo può necessitare settimane se non si risolvono i problemi di umidità alla base. È fondamentale eliminare le cause, non solo gli effetti visibili.
Il Trichoderma può tornare dopo la rimozione?
Sì, se persistono le condizioni favorevoli come elevata umidità, scarsa ventilazione o infiltrazioni d'acqua. Il fungo può ricolonizzare l'ambiente attraverso spore trasportate dall'aria esterna o da materiali contaminati non identificati. Per questo è essenziale un approccio preventivo che controlli i livelli di umidità.
È necessario evacuare casa durante la rimozione del Trichoderma?
Non sempre, ma dipende dall'estensione della contaminazione. Per piccole aree (meno di 1 metro quadro), è sufficiente isolare la zona e ventilare bene. Per infestazioni estese o in presenza di persone immunocompromesse, è consigliabile allontanarsi temporaneamente durante le operazioni di bonifica più intensive.
Il Trichoderma rappresenta una sfida importante per la salubrità domestica, ma con le giuste conoscenze e un intervento tempestivo è possibile eliminarlo efficacemente. La chiave del successo sta nell'identificazione precoce, nella rimozione professionale e nel controllo delle condizioni ambientali che ne favoriscono la crescita.
Il presente servizio è attivo esclusivamente nei seguenti comuni: Salerno, Cava de' Tirreni, Castiglione del Genovesi, Pellezzano, Vietri sul Mare, Baronissi, Fisciano, Pontecagnano Faiano, San Mango Piemonte, Cetara, Bellizzi, Nocera Inferiore, Mercato San Severino, Pagani, Battipaglia, Sant'Egidio del Monte Albino, Montoro Inferiore, Minori, Maiori, Corbara, Nocera Superiore, Eboli, Roccapiemonte, Angri, Atrani, Montecorvino Pugliano, Castel San Giorgio, Amalfi, San Valentino Torio, Solofra, San Marzano sul Sarno, Sarno, Bracigliano, Scafati, Pompei, Montoro Superiore, Siano, Sant'Antonio Abate, Santa Maria la Carità, Striano, Forino, Ravello, Gragnano, Poggiomarino, Torre Annunziata, San Cipriano Picentino, Scala, Lettere, Casola di Napoli, Praiano, Conca dei Marini, Tramonti, Serino, Castellammare di Stabia, San Giuseppe Vesuviano, Santo Stefano del Sole, Cesinali, Terzigno, Campagna, Palma Campania, Ottaviano, Aiello del Sabato, Trecase, Albanella, San Gennaro Vesuviano, Calvanico, Atripalda, Capriglia Irpina, Pimonte, Marigliano, Nola, San Paolo Bel Sito, Contursi Terme, Furore, Torre del Greco, Mariglianella, Avellino, Contrada, Vico Equense, Tufino, San Vitaliano, Scisciano, Comiziano, Saviano, Casamarciano, Camposano, San Sebastiano al Vesuvio, Somma Vesuviana, Brusciano, Palomonte, Portici, Cicciano, Acerno, Cercola, San Giorgio a Cremano, Sant'Anastasia, Pomigliano d'Arco, Oliveto Citra, Domicella, Colliano, Baiano, Montefalcione, Pratola Serra, Volla, Altavilla Silentina, Sicignano degli Alburni, Liveri, Castello di Cisterna, Polla, Agerola, Pollena Trocchia, Napoli, Cimitile, Avella, Acerra, Montefredane, San Michele di Serino, Monteforte Irpino, Mercogliano, Positano, Candida, Parolise, Lauro, Moschiano, Manocalzati, Olevano sul Tusciano, Quindici, Giffoni Valle Piana, Valva, Buccino, Giffoni Sei Casali, Visciano, Carbonara di Nola, Postiglione, Casavatore, Pertosa, Casoria, Sorbo Serpico, San Potito Ultra, Pago del Vallo di Lauro, Casalnuovo di Napoli, Romagnano al Monte, Auletta, Recale, Casagiove, San Nicola la Strada, Sant'Angelo a Scala, Marzano di Nola, Mugnano del Cardinale, Afragola, Arzano, Crispano, Casapulla, Meta, Grottolella, Ospedaletto d'Alpinolo, Taurano, Pietradefusi, Montemiletto, Capaccio, Castelcivita, Santomenna, Curti, San Prisco, Sirignano, Petina, Caserta, Capodrise, Trentinara, Torre Le Nocelle, Caivano, Cardito, Melito di Napoli, Sant'Arpino, Succivo, Sala Consilina, San Felice a Cancello, Santa Maria a Vico, Portico di Caserta, Piano di Sorrento, Montefusco, Roccarainola, Frattaminore, Frattamaggiore, Grumo Nevano, Cesa, Macerata Campania, Santa Maria Capua Vetere, San Rufo, Quadrelle, Aquara, Marcianise.